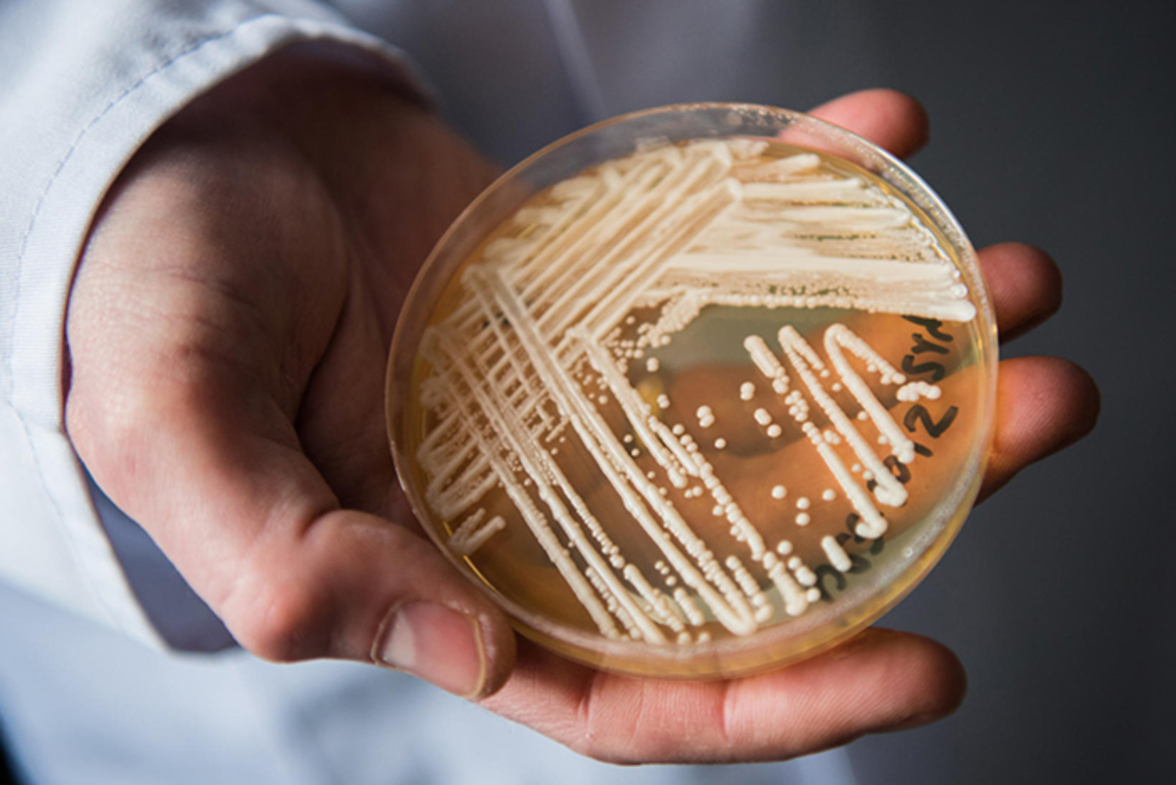
Поверхности вблизи пациентов с C. auris обычно повторно контаминировались в течение нескольких часов после уборки

Согласно результатам, представленным на весенней встрече Американского общества эпидемиологии здравоохранения, поверхности помещений, расположенных рядом с пациентами, колонизированными Candida auris, часто подвергались вторичной контаминации в течение нескольких часов после уборки или дезинфекции.
CDC предупреждает медицинские учреждения о появлении C. auris - первого вида Candida, проявившего резистентность ко всем трем основным классам противогрибковых препаратов - уже почти 6 лет. Одна из вспышек в Южной Калифорнии распространилась на девять учреждений в результате единственного случая инфицирования. "Инфекции связаны с высокой заболеваемостью и летальностью", - говорит Сара Сансом, доцент кафедры инфекционных заболеваний Медицинского центра Университета Раш. "Мы наблюдали большинство случаев заражения этим микроорганизмом в группах повышенного риска, например, в домах престарелых. Контаминация окружающей среды - это один из путей распространения C. auris в медицинских учреждениях".
Для сбора дополнительных данных, которые помогут разработать рекомендации по очищению окружающей среды и уменьшить распространение C. auris, Сансом и ее коллеги провели проспективное исследование контаминации окружающей среды, связанного с колонизацией C. auris среди пациентов и пациентов четырех учреждений длительного ухода и одной больницы неотложной помощи. Они взяли образцы с участков тела участников исследования и поверхностей вокруг них до уборки и дезинфекции их палат, после чего была проведена целенаправленная обработка поверхностей с помощью салфеток с перекисью водорода. Затем они отбирали образцы с поверхностей, к которым прикасались, сразу после уборки и каждые 4 часа в течение 12 часов.
Колонизация C. auris была наиболее распространена в носовых ходах (72%) и на ладонях/кончиках пальцев (72%) пациентов, а также была распространена ко-колонизация участков тела другими мультирезистентными организмами, сообщили Сансом и коллеги. Поверхности, расположенные в непосредственной близости от пациента, которые часто повторно контаминировались C. auris в течение 4 часов после уборки, включали прикроватные столики (24%), поручни кровати (24%) и кнопки дистанционного управления и вызова (19%). На поверхностях вне палаты пациента повторная контаминация встречалась редко - только в одном из 120 мазков. Кроме того, исследователи обнаружили, что сопутствующая контаминация окружающей среды была более распространена среди резистентных грамположительных организмов, таких как MRSA и ванкомицин-резистентный энтерококк, чем среди резистентных грамотрицательных микроорганизмов.
"Более частая обработка поверхностей окружающей среды вряд ли поможет контролировать контаминацию окружающей среды C. auris", - считает Сансом. "Наши результаты говорят о том, что нам необходимо изучить другие подходы к борьбе с C. auris". Она отметила, что исследователи "оценивают клинические факторы риска, которые могут повлиять на увеличение контаминации окружающей среды", и что "дезинфицирующие средства длительного действия или вмешательства, направленные на снижение бионагрузки C. auris на коже пациентов, также могут стать предметом наших будущих исследований".